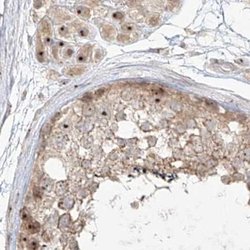
Invitrogen BYSL Polyclonal Antibody 100 &mu;L | Buy Online | Invitrogen&trade; | Fisher Scientific

missing translation for 'onlineSavingsMsg'
Learn More
Learn More
Beschreibung
Immunogen sequence: QQQEELEAEH GTGDKPAAPR ERTTRLGPRM PQDGSDDEDE EWPTLEKAAT MTAAGHHAEV VVDPEDERAI EMFMNKNPPA R Highest antigen sequence identity to the following orthologs: Mouse - 78%, Rat - 83%.
Bystin is expressed as a 2-kb major transcript and a 3.6-kb minor transcript in SNG-M cells and in human trophoblastic teratocarcinoma HT-H cells. Protein binding assays determined that bystin binds directly to trophinin and tastin, and that binding is enhanced when cytokeratins 8 and 18 are present. Immunocytochemistry of HT-H cells showed that bystin colocalizes with trophinin, tastin, and the cytokeratins, suggesting that these molecules form a complex in trophectoderm cells at the time of implantation. Using immunohistochemistry it was determined that trophinin and bystin are found in the placenta from the sixth week of pregnancy. Both proteins were localized in the cytoplasm of the syncytiotrophoblast in the chorionic villi and in endometrial decidual cells at the uteroplacental interface. After week 10, the levels of trophinin, tastin, and bystin decreased and then disappeared from placental villi.

Spezifikation
Spezifikation
| Antigen | BYSL |
| Anwendungen | Immunohistochemistry (Paraffin), Western Blot, Immunocytochemistry |
| Klassifikation | Polyclonal |
| Konzentration | 0.2 mg/mL |
| Konjugat | Unconjugated |
| Zusammensetzung | PBS with 40% glycerol and 0.02% sodium azide; pH 7.2 |
| Gen | BYSL |
| Gen-Zugriffsnummer | Q13895 |
| Gen-Alias | by the ribosomal protein s6 gene, drosophila, homolog-like; Bys; BYSL; bysl {ECO:0000312; Bystin; bystin like; bystin-like; EMBL:AAH79030.1, ECO:0000312; Enp1; RGD:727959} |
| Gensymbole | BYSL |
| Mehr anzeigen |
Name des Produkts
Indem Sie auf Absenden klicken, erklären Sie sich damit einverstanden, dass Fisher Scientific sich mit Ihnen in Verbindung setzen kann, um Ihr Feedback in diesem Formular zu bearbeiten. Wir werden Ihre Informationen nicht für andere Zwecke weitergeben. Alle bereitgestellten Kontaktinformationen werden in Übereinstimmung mit unserer Datenschutzrichtlinie aufbewahrt. Datenschutzrichtlinie.
Haben Sie Verbesserungsvorschläge?